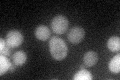
YPR118W
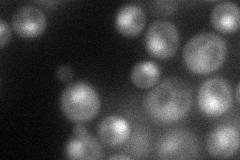
YPR118W
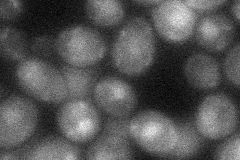
YPR118W
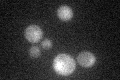
YPR118W

View description
5'-methylthioribose-1-phosphate isomerase; catalyzes the isomerization of 5-methylthioribose-1-phosphate to 5-methylthioribulose-1-phosphate in the methionine salvage pathway
Localization:
Intensity:
Fold change:
Significance:
-
C’ GFP library in SD
cytosol37.54 -
N' NOP1pr-GFP in SD
cytosol,nucleus52.7556 -
N' TEF2pr-mCherry in SD

cytosol,nucleus63.5978 -
N' NATIVEpr-GFP in SD

cytosol,punctate23.8003 -
N' TEF2pr-VC and Cyto-VN in SD
nucleus32.1305 -
C’ GFP library in SD+DTT

cytosol34.60.92No -
C’ GFP library in SD+H2O2

cytosol49.71.32No -
C’ GFP library in Starvation Media
cytosol26.910.71No -
C’ GFP library on the background of Pup2-DaMP

cytosol -
C’ GFP library on the background of CCT mutant

cytosol32.30310.860135No
